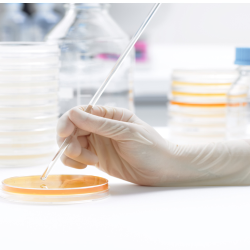

進口食品檢驗
產品分類:媒體與相關服務
廠商名稱:日本食品分析中心
攤位號碼:N1009
產品特色
JFRL is accredited by the Ministry of Health, Labour and Welfare (MHLW) as a testing laboratory to inspect imported foods for pesticides, antibiotics, heavy metals, environmental contaminants, aflatoxin, and food additives.
相關產品
您可能有興趣的產品
人氣產品專區